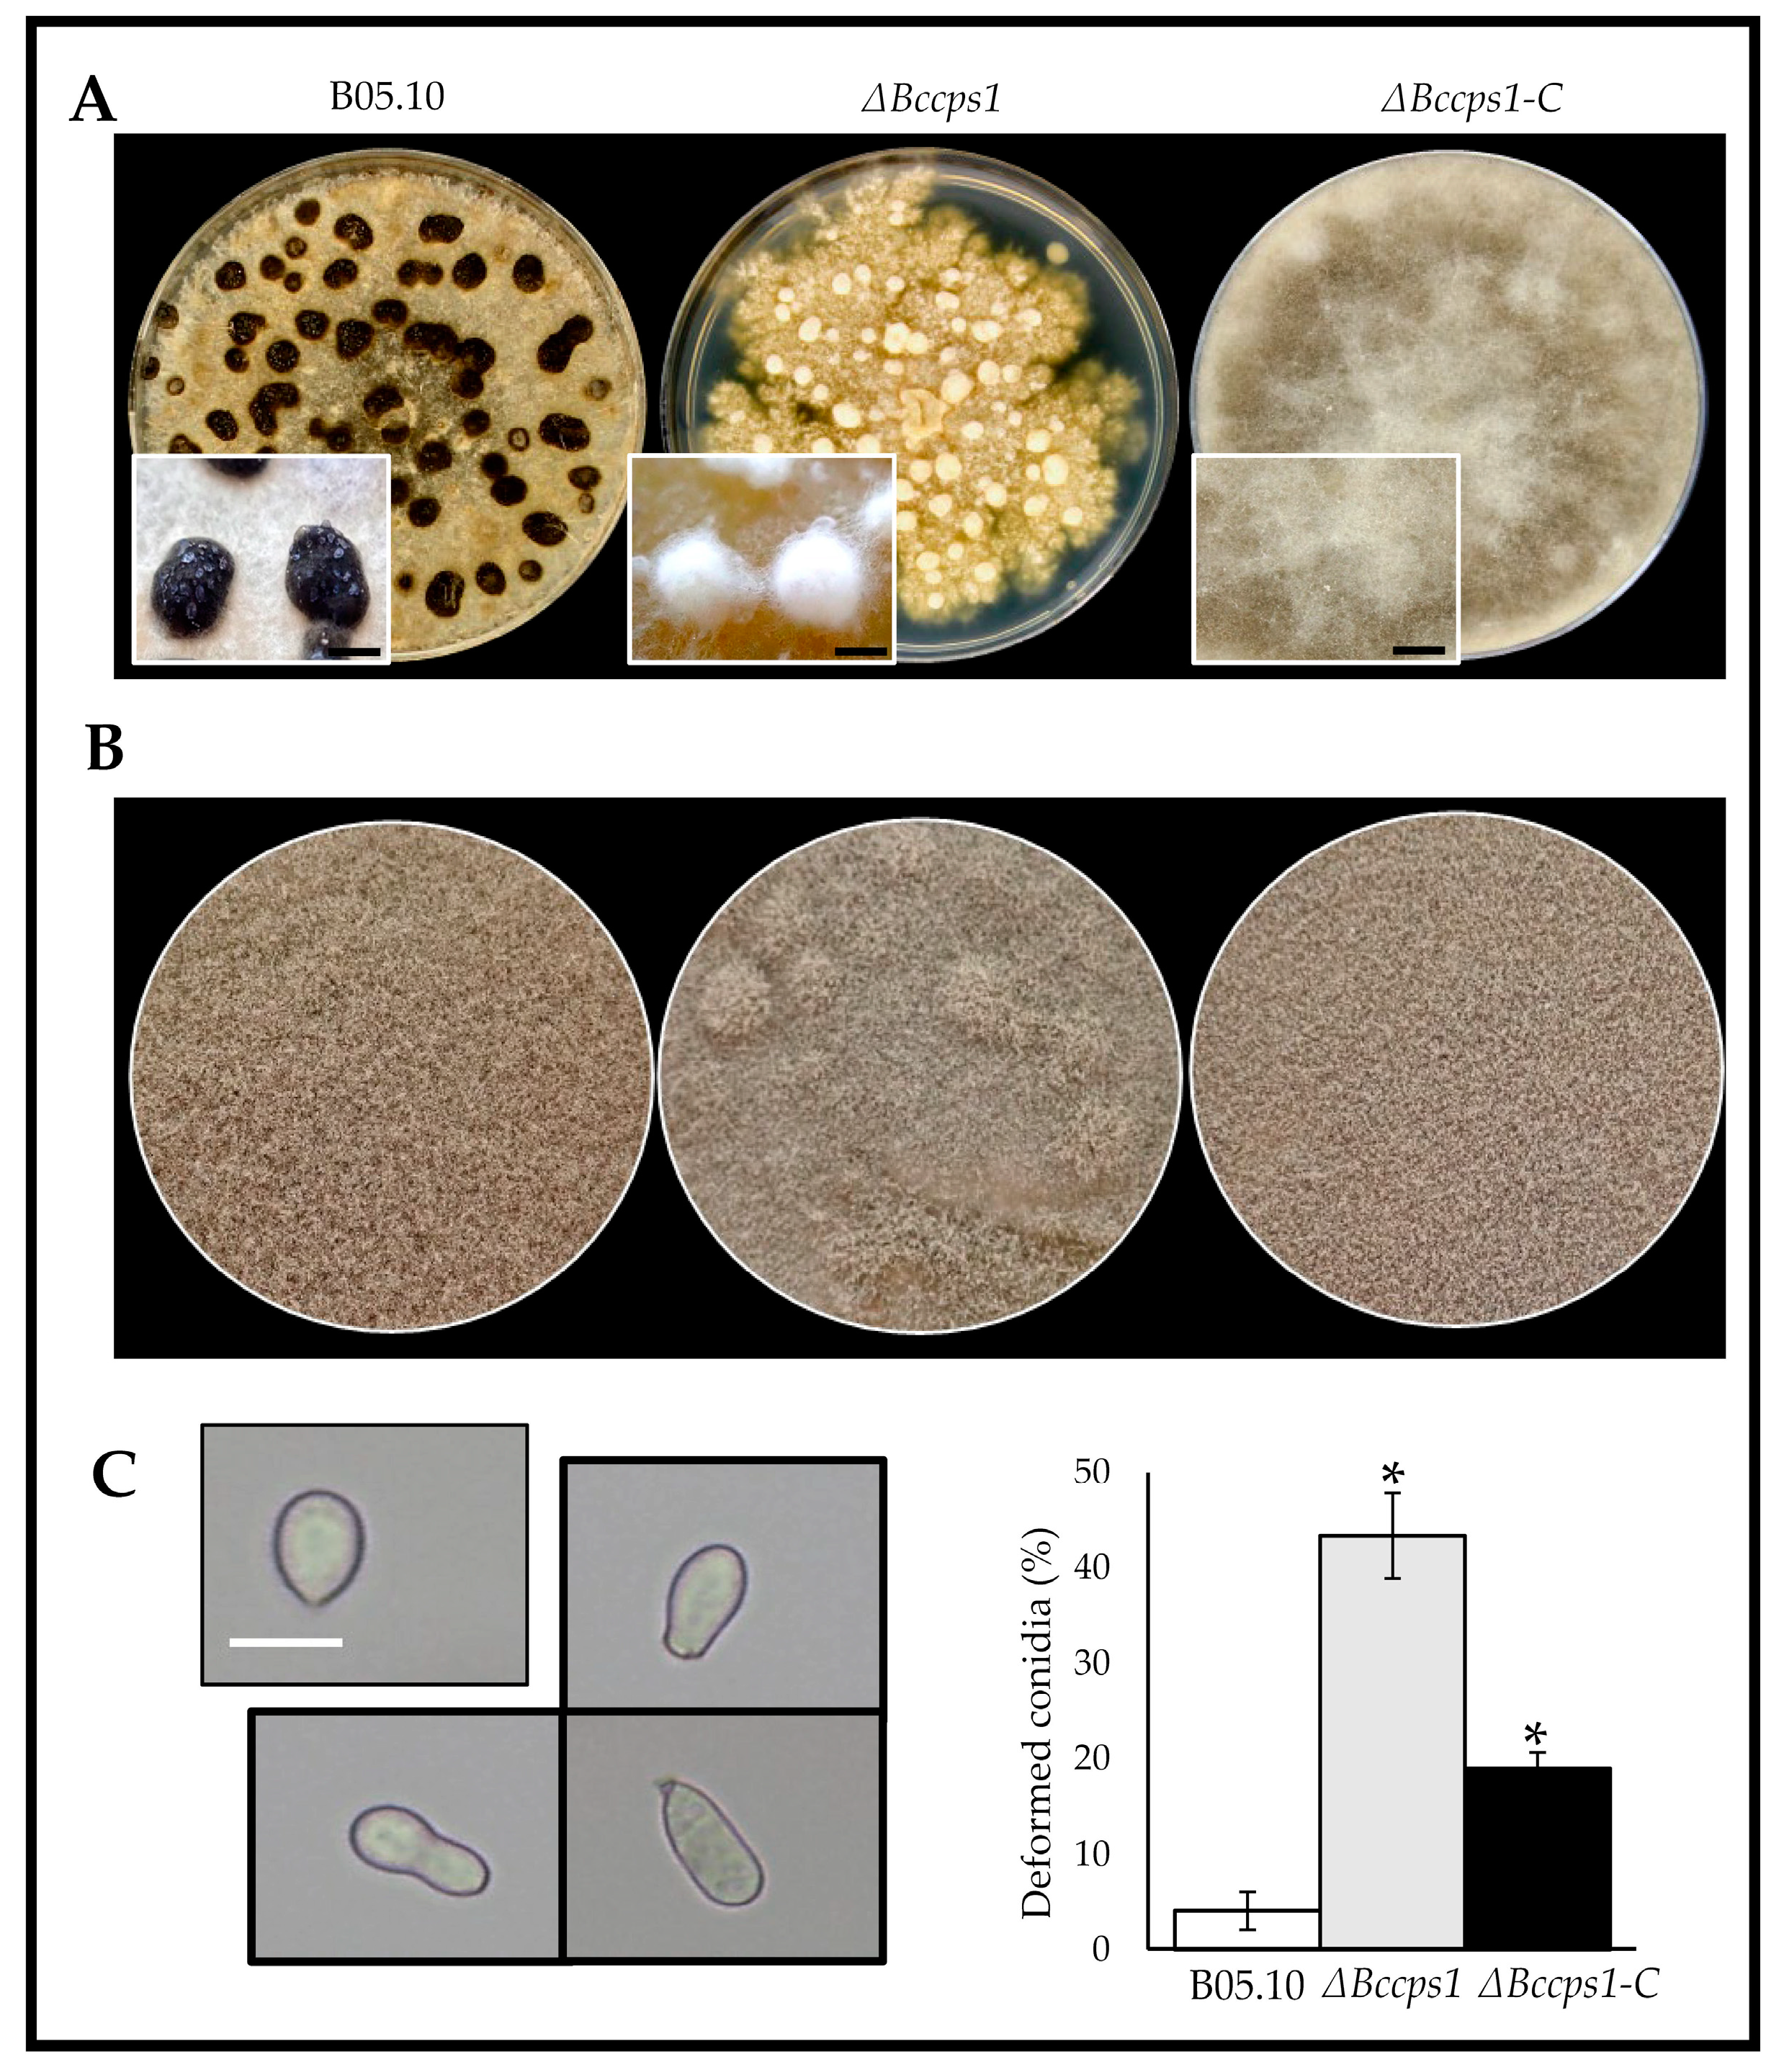
Jof 08 00899 g004 Jof 08 00899 g004

Evidencing New Roles for the Glycosyl-Transferase Cps1 in the Phytopathogenic Fungus Botrytis cinerea
Abstract
1. Introduction
2. Materials and Methods
2.1. Strains and Culture Conditions
2.2. Sclerotial Development, Conidiation and Germination Assays
2.3. Bioinformatic Analyses
2.4. Plasmid Constructions and Quantitative Real Time PCR
2.5. Fungal Transformation and Mutant Purification
2.6. Southern Blot
2.7. Cell Wall Extracts Preparation
2.8. Cell Wall Composition Analysis
2.9. Plant Infection and Adhesion Assays
2.10. Label-Free Quantitative Proteomics
2.11. Activities of Secreted Enzymes
3. Results
3.1. The Botrytis Cps-Encoding Genes
3.2. Deletion of the Bccps1 Gene and Localization of the BcCps1 Protein
3.3. Role of BcCps1 in Mycelial Growth
3.4. Role of BcCps1 in Sclerotia Formation, in Conidiation and in Germination
3.5. Role of BcCps1 in Cell Wall Integrity and Composition
3.6. Exoproteome Analysis of the ΔBccps1 Mutant Strain
3.7. Role of BcCps1 in the Interaction of B. cinerea with a Host Plant
4. Discussion
4.1. BcCps1 Is Required for Normal Composition and Integrity of the Fungal Cell Wall
4.2. BcCps1 Is Involved in Hyphal Adherence and Reveals a Two-Phase Hyphal Growth on Solid Surfaces
4.3. BcCps1 Is Involved in Conidial and Sclerotial Differentiation
4.4. BcCps1 Is Involved in Virulence
5. Conclusions
Supplementary Materials
Author Contributions
Funding
Institutional Review Board Statement
Informed Consent Statement
Data Availability Statement
Acknowledgments
Conflicts of Interest
References
- Ao, J.; Free, S.J. Genetic and biochemical characterization of the GH72 family of cell wall transglycosylases in Neurospora crassa. Fungal Genet. Biol. 2017, 101, 46–54. [Google Scholar] [CrossRef] [PubMed]
- Latgé, J.-P. The cell wall: A carbohydrate armour for the fungal cell. Mol. Microbiol. 2007, 66, 279–290. [Google Scholar] [CrossRef] [PubMed]
- Patel, P.; Free, S.J. Characterization of Neurospora crassa GH16, GH17, and GH72 gene families of cell wall crosslinking enzymes. Cell Surf. 2022, 8, 100073. [Google Scholar] [CrossRef] [PubMed]
- Latgé, J.-P.; Beauvais, A.; Chamilos, G. The Cell Wall of the Human Fungal Pathogen Aspergillus fumigatus: Biosynthesis, Organization, Immune Response, and Virulence. Annu. Rev. Microbiol. 2017, 71, 99–116. [Google Scholar] [CrossRef]
- Samar, D.; Kieler, J.B.; Klutts, J.S. Identification and Deletion of Tft1, a Predicted Glycosyltransferase Necessary for Cell Wall β-1,3;1,4-Glucan Synthesis in Aspergillus fumigatus. PLoS ONE 2015, 10, e0117336. [Google Scholar] [CrossRef]
- Chakraborty, A.; Fernando, L.D.; Fang, W.; Widanage, M.C.D.; Wei, P.; Jin, C.; Fontaine, T.; Latgé, J.-P.; Wang, T. A molecular vision of fungal cell wall organization by functional genomics and solid-state NMR. Nat. Commun. 2021, 12, 6346. [Google Scholar] [CrossRef]
- Fajardo-Somera, R.A.; Jöhnk, B.; Bayram, Ö.; Valerius, O.; Braus, G.H.; Riquelme, M. Dissecting the function of the different chitin synthases in vegetative growth and sexual development in Neurospora crassa. Fungal Genet. Biol. 2015, 75, 30–45. [Google Scholar] [CrossRef]
- Latgé, J.-P.; Beauvais, A. Functional duality of the cell wall. Curr. Opin. Microbiol. 2014, 20, 111–117. [Google Scholar] [CrossRef]
- Drula, E.; Garron, M.-L.; Dogan, S.; Lombard, V.; Henrissat, B.; Terrapon, N. The carbohydrate-active enzyme database: Functions and literature. Nucleic Acids Res. 2022, 50, D571–D577. [Google Scholar] [CrossRef]
- Mestrom, L.; Przypis, M.; Kowalczykiewicz, D.; Pollender, A.; Kumpf, A.; Marsden, S.R.; Bento, I.; Jarzębski, A.B.; Szymańska, K.; Chruściel, A.; et al. Leloir Glycosyltransferases in Applied Biocatalysis: A Multidisciplinary Approach. Int. J. Mol. Sci. 2019, 20, 5263. [Google Scholar] [CrossRef]
- Gonçalves, I.R.; Brouillet, S.; Soulié, M.-C.; Gribaldo, S.; Sirven, C.; Charron, N.; Boccara, M.; Choquer, M. Genome-wide analyses of chitin synthases identify horizontal gene transfers towards bacteria and allow a robust and unifying classification into fungi. BMC Evol. Biol. 2016, 16, 252. [Google Scholar] [CrossRef] [PubMed]
- Garcia-Rubio, R.; De Oliveira, H.C.; Rivera, J.; Trevijano-Contador, N. The Fungal Cell Wall: Candida, Cryptococcus, and Aspergillus Species. Front. Microbiol. 2020, 10, 2993. [Google Scholar] [CrossRef] [PubMed]
- Choquer, M.; Rascle, C.; Gonçalves, I.R.; de Vallée, A.; Ribot, C.; Loisel, E.; Smilevski, P.; Ferria, J.; Savadogo, M.; Souibgui, E.; et al. The infection cushion of Botrytis cinerea: A fungal ‘weapon’ of plant-biomass destruction. Environ. Microbiol. 2021, 23, 2293–2314. [Google Scholar] [CrossRef] [PubMed]
- Magellan, H.; Boccara, M.; Drujon, T.; Soulié, M.-C.; Guillou, C.; Dubois, J.; Becker, H.F. Discovery of two new inhibitors of Botrytis cinerea chitin synthase by a chemical library screening. Bioorg. Med. Chem. 2013, 21, 4997–5003. [Google Scholar] [CrossRef] [PubMed]
- Soulié, M.-C.; Piffeteau, A.; Choquer, M.; Boccara, M.; Vidal-Cros, A. Disruption of Botrytis cinerea class I chitin synthase gene Bcchs1 results in cell wall weakening and reduced virulence. Fungal Genet. Biol. 2003, 40, 38–46. [Google Scholar] [CrossRef]
- Soulie, M.-C.; Perino, C.; Piffeteau, A.; Choquer, M.; Malfatti, P.; Cimerman, A.; Kunz, C.; Boccara, M.; Vidal-Cros, A. Botrytis cinerea virulence is drastically reduced after disruption of chitin synthase class III gene (Bcchs3a). Cell. Microbiol. 2006, 8, 1310–1321. [Google Scholar] [CrossRef]
- Arbelet, D.; Malfatti, P.; Simond-Côte, E.; Fontaine, T.; Desquilbet, L.; Expert, D.; Kunz, C.; Soulié, M.-C. Disruption of the Bcchs3a Chitin Synthase Gene in Botrytis cinerea Is Responsible for Altered Adhesion and Overstimulation of Host Plant Immunity. Mol. Plant-Microbe Interact. 2010, 23, 1324–1334. [Google Scholar] [CrossRef][Green Version]
- Cui, Z.; Ding, Z.; Yang, X.; Wang, K.; Zhu, T. Gene disruption and characterization of a class V chitin synthase in Botrytis cinerea. Can. J. Microbiol. 2009, 55, 1267–1274. [Google Scholar] [CrossRef]
- Cui, Z.; Wang, Y.; Lei, N.; Wang, K.; Zhu, T. Botrytis cinerea chitin synthase BcChsVI is required for normal growth and pathogenicity. Curr. Genet. 2013, 59, 119–128. [Google Scholar] [CrossRef]
- Morcx, S.; Kunz, C.; Choquer, M.; Assie, S.; Blondet, E.; Simond-Côte, E.; Gajek, K.; Chapeland-Leclerc, F.; Expert, D.; Soulie, M.-C. Disruption of Bcchs4, Bcchs6 or Bcchs7 chitin synthase genes in Botrytis cinerea and the essential role of class VI chitin synthase (Bcchs6). Fungal Genet. Biol. 2013, 52, 1–8. [Google Scholar] [CrossRef]
- Jong, A.; Wu, C.-H.; Chen, H.-M.; Luo, F.; Kwon-Chung, K.J.; Chang, Y.C.; LaMunyon, C.W.; Plaas, A.; Huang, S.-H. Identification and Characterization of CPS1 as a Hyaluronic Acid Synthase Contributing to the Pathogenesis of Cryptococcus neoformans Infection. Eukaryot. Cell 2007, 6, 1486–1496. [Google Scholar] [CrossRef] [PubMed]
- Chang, Y.C.; Jong, A.; Huang, S.; Zerfas, P.; Kwon-Chung, K.J. CPS1, a Homolog of the Streptococcus pneumoniae Type 3 Polysaccharide Synthase Gene, Is Important for the Pathobiology of Cryptococcus neoformans. Infect. Immun. 2006, 74, 3930–3938. [Google Scholar] [CrossRef] [PubMed]
- Nepal, B.; Myers, R.; Lohmar, J.M.; Puel, O.; Thompson, B.; Van Cura, M.; Calvo, A.M. Characterization of the putative polysaccharide synthase CpsA and its effects on the virulence of the human pathogen Aspergillus fumigatus. PLoS ONE 2019, 14, e0216092. [Google Scholar] [CrossRef]
- Deng, S.; Sun, W.; Dong, L.; Cui, G.; Deng, Y.Z. MoGT2 Is Essential for Morphogenesis and Pathogenicity of Magnaporthe oryzae. mSphere 2019, 4, e00309-19. [Google Scholar] [CrossRef]
- Deng, Q.; Wu, H.; Gu, Q.; Tang, G.; Liu, W. Glycosyltransferase FvCpsA Regulates Fumonisin Biosynthesis and Virulence in Fusarium verticillioides. Toxins 2021, 13, 718. [Google Scholar] [CrossRef] [PubMed]
- Wang, S.; Yuan, A.; Zeng, L.; Hou, S.; Wang, M.; Li, L.; Cai, Z.; Zhong, G. The putative polysaccharide synthase AfCps1 regulates Aspergillus fumigatus morphogenesis and conidia immune response in mouse bone marrow-derived macrophages. J. Microbiol. 2021, 59, 64–75. [Google Scholar] [CrossRef] [PubMed]
- Ogawa, M.; Wada, H.; Yoshimura, T.; Sato, A.; Fukuda, R.; Koyama, Y.; Horiuchi, H. Deletion of Aspergillus nidulans cpsA/rseA induces increased extracellular hydrolase production in solid-state culture partly through the high osmolarity glycerol pathway. J. Biosci. Bioeng. 2021, 131, 589–598. [Google Scholar] [CrossRef]
- King, R.; Urban, M.; Lauder, R.P.; Hawkins, N.; Evans, M.; Plummer, A.; Halsey, K.; Lovegrove, A.; Hammond-Kosack, K.; Rudd, J.J. A conserved fungal glycosyltransferase facilitates pathogenesis of plants by enabling hyphal growth on solid surfaces. PLoS Pathog. 2017, 13, e1006672. [Google Scholar] [CrossRef]
- Feng, X.; Ramamoorthy, V.; Pandit, S.S.; Prieto, A.; Espeso, E.A.; Calvo, A.M. cpsA regulates mycotoxin production, morphogenesis and cell wall biosynthesis in the fungus Aspergillus nidulans. Mol. Microbiol. 2017, 105, 1–24. [Google Scholar] [CrossRef]
- Fu, C.; Sokolow, E.; Rupert, C.B.; Free, S.J. The Neurospora crassa CPS-1 polysaccharide synthase functions in cell wall biosynthesis. Fungal Genet. Biol. 2014, 69, 23–30. [Google Scholar] [CrossRef]
- Lalève, A.; Gamet, S.; Walker, A.-S.; Debieu, D.; Toquin, V.; Fillinger, S. Site-directed mutagenesis of the P225, N230 and H272 residues of succinate dehydrogenase subunit B from Botrytis cinerea highlights different roles in enzyme activity and inhibitor binding. Environ. Microbiol. 2014, 16, 2253–2266. [Google Scholar] [CrossRef] [PubMed]
- Altschul, S.F.; Madden, T.L.; Schäffer, A.A.; Zhang, J.; Zhang, Z.; Miller, W.; Lipman, D.J. Gapped BLAST and PSI-BLAST: A new generation of protein database search programs. Nucleic Acids Res. 1997, 25, 3389–3402. [Google Scholar] [CrossRef] [PubMed]
- Rolland, S.; Jobic, C.; Fèvre, M.; Bruel, C. Agrobacterium-mediated transformation of Botrytis cinerea, simple purification of monokaryotic transformants and rapid conidia-based identification of the transfer-DNA host genomic DNA flanking sequences. Curr. Genet. 2003, 44, 164–171. [Google Scholar] [CrossRef]
- Katoh, K.; Rozewicki, J.; Yamada, K.D. MAFFT online service: Multiple sequence alignment, interactive sequence choice and visualization. Brief. Bioinform. 2019, 20, 1160–1166. [Google Scholar] [CrossRef]
- Criscuolo, A.; Gribaldo, S. BMGE (Block Mapping and Gathering with Entropy): A new software for selection of phylogenetic informative regions from multiple sequence alignments. BMC Evol. Biol. 2010, 10, 210. [Google Scholar] [CrossRef] [PubMed]
- Tsirigos, K.D.; Peters, C.; Shu, N.; Käll, L.; Elofsson, A. The TOPCONS web server for consensus prediction of membrane protein topology and signal peptides. Nucleic Acids Res. 2015, 43, W401–W407. [Google Scholar] [CrossRef]
- García-Nafría, J.; Watson, J.F.; Greger, I.H. IVA cloning: A single-tube universal cloning system exploiting bacterial In Vivo Assembly. Sci. Rep. 2016, 6, 27459. [Google Scholar] [CrossRef]
- Hernanz-Koers, M.; Gandía, M.; Garrigues, S.; Manzanares, P.; Yenush, L.; Orzaez, D.; Marcos, J.F. FungalBraid: A GoldenBraid-based modular cloning platform for the assembly and exchange of DNA elements tailored to fungal synthetic biology. Fungal Genet. Biol. 2018, 116, 51–61. [Google Scholar] [CrossRef]
- Livak, K.J.; Schmittgen, T.D. Analysis of relative gene expression data using real-time quantitative PCR and the 2−ΔΔCT Method. Methods 2001, 25, 402–408. [Google Scholar] [CrossRef]
- Mouyna, I.; Hartl, L.; Latgé, J.-P. β-1,3-Glucan Modifying Enzymes in Aspergillus fumigatus. Front. Microbiol. 2013, 4, 81. [Google Scholar] [CrossRef]
- Maddi, A.; Free, S.J. α-1,6-Mannosylation of N-Linked Oligosaccharide Present on Cell Wall Proteins Is Required for Their Incorporation into the Cell Wall in the Filamentous Fungus Neurospora crassa. Eukaryot. Cell 2010, 9, 1766–1775. [Google Scholar] [CrossRef] [PubMed]
- Schiavone, M.; Vax, A.; Formosa, C.; Martin-Yken, H.; Dague, E.; François, J.M. A combined chemical and enzymatic method to determine quantitatively the polysaccharide components in the cell wall of yeasts. FEMS Yeast Res. 2014, 14, 933–947. [Google Scholar] [CrossRef] [PubMed]
- Mouyna, I.; Morelle, W.; Vai, M.; Monod, M.; Léchenne, B.; Fontaine, T.; Beauvais, A.; Sarfati, J.; Prévost, M.-C.; Henry, C.; et al. Deletion of GEL2 encoding for a β(1-3)glucanosyltransferase affects morphogenesis and virulence in Aspergillus fumigatus. Mol. Microbiol. 2005, 56, 1675–1688. [Google Scholar] [CrossRef]
- Rascle, C.; Dieryckx, C.; Dupuy, J.W.; Muszkieta, L.; Souibgui, E.; Droux, M.; Bruel, C.; Girard, V.; Poussereau, N. The pH regulator PacC: A host-dependent virulence factor in Botrytis cinerea. Environ. Microbiol. Rep. 2018, 10, 555–568. [Google Scholar] [CrossRef] [PubMed]
- Käll, L.; Canterbury, J.D.; Weston, J.; Noble, W.S.; MacCoss, M.J. Semi-supervised learning for peptide identification from shotgun proteomics datasets. Nat. Methods 2007, 4, 923–925. [Google Scholar] [CrossRef] [PubMed]
- Deutsch, E.W.; Bandeira, N.; Sharma, V.; Perez-Riverol, Y.; Carver, J.J.; Kundu, D.J.; García-Seisdedos, D.; Jarnuczak, A.F.; Hewapathirana, S.; Pullman, B.S.; et al. The ProteomeXchange consortium in 2020: Enabling ‘big data’ approaches in proteomics. Nucleic Acids Res. 2020, 48, D1145–D1152. [Google Scholar] [CrossRef] [PubMed]
- De Vallée, A.; Bally, P.; Bruel, C.; Chandat, L.; Choquer, M.; Dieryckx, C.; Dupuy, J.-W.; Kaiser, S.; Latorse, M.-P.; Loisel, E.; et al. A Similar Secretome Disturbance as a Hallmark of Non-pathogenic Botrytis cinerea ATMT-Mutants? Front. Microbiol. 2019, 10, 2829. [Google Scholar] [CrossRef]
- Lionetti, V. PECTOPLATE: The simultaneous phenotyping of pectin methylesterases, pectinases, and oligogalacturonides in plants during biotic stresses. Front. Plant Sci. 2015, 6, 331. [Google Scholar] [CrossRef]
- Leroch, M.; Kleber, A.; Silva, E.; Coenen, T.; Koppenhöfer, D.; Shmaryahu, A.; Valenzuela, P.D.T.; Hahn, M. Transcriptome Profiling of Botrytis cinerea Conidial Germination Reveals Upregulation of Infection-Related Genes during the Prepenetration Stage. Eukaryot. Cell 2013, 12, 614–626. [Google Scholar] [CrossRef]
- Leroch, M.; Mernke, D.; Koppenhoefer, D.; Schneider, P.; Mosbach, A.; Doehlemann, G.; Hahn, M. Living Colors in the Gray Mold Pathogen Botrytis cinerea: Codon-Optimized Genes Encoding Green Fluorescent Protein and mCherry, Which Exhibit Bright Fluorescence. Appl. Environ. Microbiol. 2011, 77, 2887–2897. [Google Scholar] [CrossRef]
- Wood, P.J.; Fulcher, R. Specific interaction of aniline blue with (1 → 3)-β-D-glucan. Carbohydr. Polym. 1984, 4, 49–72. [Google Scholar] [CrossRef]
- Saleemuddin, M.; Husain, Q. Concanavalin A: A useful ligand for glycoenzyme immobilization—A review. Enzym. Microb. Technol. 1991, 13, 290–295. [Google Scholar] [CrossRef]
- Zemanek, G.; Jagusiak, A.; Chłopaś, K.; Piekarska, B.; Stopa, B. Congo red fluorescence upon binding to macromolecules–A possible explanation for the enhanced intensity. Bio-Algorithms Med-Syst. 2017, 13, 69–78. [Google Scholar] [CrossRef]
- Henriques, B.S.; Garcia, E.S.; Azambuja, P.; Genta, F.A. Determination of Chitin Content in Insects: An Alternate Method Based on Calcofluor Staining. Front. Physiol. 2020, 11, 117. [Google Scholar] [CrossRef]
- Almagro Armenteros, J.J.; Tsirigos, K.D.; Sønderby, C.K.; Petersen, T.N.; Winther, O.; Brunak, S.; Von Heijne, G.; Nielsen, H. SignalP 5.0 improves signal peptide predictions using deep neural networks. Nat. Biotechnol. 2019, 37, 420–423. [Google Scholar] [CrossRef]
- Bi, K.; Scalschi, L.; Jaiswal, N.; Mengiste, T.; Fried, R.; Sanz, A.B.; Arroyo, J.; Zhu, W.; Masrati, G.; Sharon, A. The Botrytis cinerea Crh1 transglycosylase is a cytoplasmic effector triggering plant cell death and defense response. Nat. Commun. 2021, 12, 2166. [Google Scholar] [CrossRef]
- Gow, N.A.R.; Latge, J.-P.; Munro, C.A. The Fungal Cell Wall: Structure, Biosynthesis, and Function. Microbiol. Spectr. 2017, 5, 1–25. [Google Scholar] [CrossRef]
- Lipke, P.N. What We Do Not Know about Fungal Cell Adhesion Molecules. J. Fungi 2018, 4, 59. [Google Scholar] [CrossRef]
- Gravelat, F.N.; Beauvais, A.; Liu, H.; Lee, M.J.; Snarr, B.D.; Chen, D.; Xu, W.; Kravtsov, I.; Hoareau, C.M.Q.; Vanier, G.; et al. Aspergillus Galactosaminogalactan Mediates Adherence to Host Constituents and Conceals Hyphal β-Glucan from the Immune System. PLoS Pathog. 2013, 9, e1003575. [Google Scholar] [CrossRef]
- Miyazawa, K.; Yoshimi, A.; Sano, M.; Tabata, F.; Sugahara, A.; Kasahara, S.; Koizumi, A.; Yano, S.; Nakajima, T.; Abe, K. Both Galactosaminogalactan and α-1,3-Glucan Contribute to Aggregation of Aspergillus oryzae Hyphae in Liquid Culture. Front. Microbiol. 2019, 10, 2090. [Google Scholar] [CrossRef]
- Schumacher, J. DHN melanin biosynthesis in the plant pathogenic fungus Botrytis cinerea is based on two developmentally regulated key enzyme (PKS)-encoding genes. Mol. Microbiol. 2016, 99, 729–748. [Google Scholar] [CrossRef] [PubMed]
- Nitiu, D.S.; Mallo, A.C.; Saparrat, M.C.N. Fungal melanins that deteriorate paper cultural heritage: An overview. Mycologia 2020, 112, 859–870. [Google Scholar] [CrossRef] [PubMed]

Publisher’s Note: MDPI stays neutral with regard to jurisdictional claims in published maps and institutional affiliations. |
© 2022 by the authors. Licensee MDPI, Basel, Switzerland. This article is an open access article distributed under the terms and conditions of the Creative Commons Attribution (CC BY) license (https://creativecommons.org/licenses/by/4.0/).
Share and Cite
Blandenet, M.; Gonçalves, I.R.; Rascle, C.; Dupuy, J.-W.; Gillet, F.-X.; Poussereau, N.; Choquer, M.; Bruel, C. Evidencing New Roles for the Glycosyl-Transferase Cps1 in the Phytopathogenic Fungus Botrytis cinerea. J. Fungi 2022, 8, 899. https://doi.org/10.3390/jof8090899
Blandenet M, Gonçalves IR, Rascle C, Dupuy J-W, Gillet F-X, Poussereau N, Choquer M, Bruel C. Evidencing New Roles for the Glycosyl-Transferase Cps1 in the Phytopathogenic Fungus Botrytis cinerea. Journal of Fungi. 2022; 8(9):899. https://doi.org/10.3390/jof8090899
Chicago/Turabian StyleBlandenet, Matthieu, Isabelle R. Gonçalves, Christine Rascle, Jean-William Dupuy, François-Xavier Gillet, Nathalie Poussereau, Mathias Choquer, and Christophe Bruel. 2022. "Evidencing New Roles for the Glycosyl-Transferase Cps1 in the Phytopathogenic Fungus Botrytis cinerea" Journal of Fungi 8, no. 9: 899. https://doi.org/10.3390/jof8090899
APA StyleBlandenet, M., Gonçalves, I. R., Rascle, C., Dupuy, J.-W., Gillet, F.-X., Poussereau, N., Choquer, M., & Bruel, C. (2022). Evidencing New Roles for the Glycosyl-Transferase Cps1 in the Phytopathogenic Fungus Botrytis cinerea. Journal of Fungi, 8(9), 899. https://doi.org/10.3390/jof8090899

